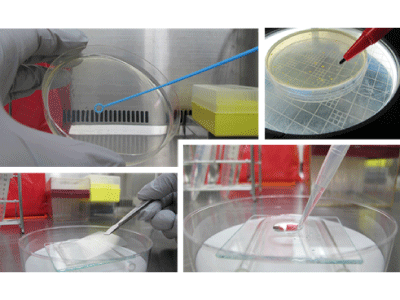
繰返し除菌性評価試験サービスのイメージ写真

繰返し除菌性評価試験サービスのご案内
今までの抗菌・抗ウイルス性能評価サービスに加え、繰返し除菌性能評価サービス(JIS Z 2811及びその応用試験)を開始いたしました。
是非ご相談、ご利用ください。
【試験料金】
9,000円(税別)×試験ポイント数
【速報納期(目安)】
試験申込書・サンプル受領後1~3週間程度
※あくまで目安です。お申込み時の混雑状況により変動します。
*「速報納期」とは:正式な「報告書」を発行・発送する前の「速報」の試験結果報告(PDF)送付目安です。
【繰返し除菌性評価試験の概要】
本試験ではサンプル表面に付着した菌を繰り返し拭き取った後も、菌に対するサンプルの効果が持続・維持される性質(繰返し除菌性)を評価します。
- サンプル表面に菌液を滴下し、フィルムを被せて培養します。
- 一定時間培養後に菌液をろ紙で拭き取り、再び菌液を滴下し、フィルムを被せて培養します。これを繰り返します。
- 所定回数繰り返し後、培地で菌を洗い出し、寒天培地と混和して培養します。
- 出現するコロニー数を数え、生菌数を算出することで繰返し除菌性を評価します。
ご相談・お問い合わせ・抗かび性能評価以外も含めた抗菌・抗ウイルス性能評価の詳細につきましては
以下ページをご参照ください。
※お問い合わせ・ご相談は上記ボタンのページにてご確認ください。
担当部署:研究開発部・殿町評価事業課・評価センターグループ
